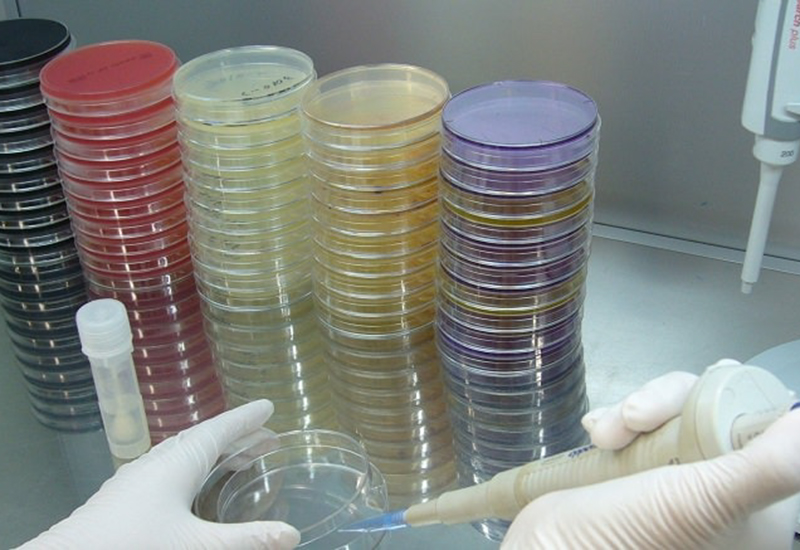

衛生点検

衛生管理の見える化で、安全・安心な施設運営を
食中毒や院内感染などのリスク対策として、施設内の衛生状態を「数値で可視化」する検査が求められています。
環境未来では、ATPふき取り検査や細菌ふき取り検査を通じて、厨房・作業場・共用部の衛生状態を評価し、衛生管理のPDCAサイクル構築を支援します。
保菌検査
症状が出ていない場合でも食中毒等の原因となる細菌を保有(保菌)している場合があるため、早期発見し、保菌者からの二次感染を防止するために保菌検査が必要となります。とくに食品を扱う施設で働く方は定期的に検査を行います。
腸内細菌(検便)検査
腸内細菌検査は、症状が出ていない場合でも食中毒等の原因となる細菌を保有(保菌)している場合があるため、早期発見し、保菌者からの二次感染を未然に防止する意味で不可欠な検査です。
定期的に検査を行い、食中毒発生のリスクを低減させる安心安全な衛生管理が求められています。
便中のO157、O111、O26、サルモネラ、赤痢、腸炎ビブリオ、ノロウイルス、キャンピロバクター、コレラの検査が可能です。調理者、介護士、保育士が食中毒菌を持っていないことを確かめるための検査です。
ノロウイルス検査
ノロウイルスは主に、10月頃から流行がはじまり、12月~1月でピークを迎えます。食品からの汚染だけでなく人から人への感染も多く、集客施設などでは、感染予防に向けた万全な衛生管理が必要になってきます。
弊社ではノロウイルスの高感度のRT-PCR法による検査を行っております。大量調理マニュアルの適応を受ける施設で働く調理師が職場復帰するための検査にも対応しています。

落下細菌検査
落下細菌(らっかさいきん)とは、空気中に浮遊している微生物(細菌やカビなど)が、重力によって自然に地面や物体の表面へ落下したものです。
この落下細菌を測定することで、その場所の空気の清浄度や衛生状態を評価することができます。検査は、特定の場所に培地(シャーレ)を一定時間設置し、落下した微生物を捕集・培養することで行われます。
空気中の微生物は、目には見えませんが、製品に付着して**品質に大きな影響を及ぼす(汚染する)**可能性があります。そのため、製造環境全体の微生物汚染の実態を正確に調査し、製品への汚染度や汚染経路を把握することが、品質管理において非常に重要となります。

衛生点検コンサルティング
食の安全を守るため、給食提供施設や食品工場には、衛生状態の正しい把握と継続的な改善が不可欠です。
環境未来の専門スタッフが現場の衛生状況を調査し、目に見えないリスクを可視化します。その結果に基づき、具体的な改善提案や衛生管理ルールの策定サポートを実施。
定期的な調査と専門的な指導を通じて、食中毒やクレームにつながるリスクを早期に発見し、安心できる衛生環境の継続的な維持・向上をお手伝いします。

検査対象者
- 飲食店、旅館、食品製造販売業食品を扱う業務に従事する方
- 学校、保育園、保育所、病院などの集団給食業務に従事する方
- 水道事業に従事する方
- 介護施設、デイサービス、特別老人ホームなどで調理などに携わる方
参考
「大量調理施設衛生管理マニュアル」(厚生労働省)においては、大量調理施設の調理従事者などは月に1回以上の検便を受けること。検便検査には、腸管出血性大腸菌の検査を含めること。また、必要に応じて10月から3月にはノロウイルスの検査を含めることが望ましいこと」と記載されています。
「学校給食衛生管理の基準」(文部科学省。一部改訂:平成20年7月)には、学校給食従事者の健康管理として、「検便は、月2回以上実施されていること」と記載されています。
オンライン申し込み
弊社では全国の皆様がお手軽に検査できるようオンラインショップによる申込も受け付けています。申し込みによる検査も行っております。近くに検査ができるところがない方、業務が忙しいので効率的に検査を実施したい方など是非ご検討ください。
ノロウイルスについて
ノロウイルスとは?
- 非常に小さなウイルスで、激しい嘔吐や下痢を1〜2日程度引き起こします。
- 人から人への接触感染、食品を介した感染、飛沫感染など、様々な経路で簡単に蔓延します。
潜伏期間と症状
- 潜伏期間: 感染してから症状が出るまでおよそ24〜48時間です。
- 主な症状: 下痢、嘔吐、腹痛、発熱など。
- 特長: 吐き気が突発的に襲ってくるため、床などを汚染しやすく、そこから感染が拡大する原因になります。
- 注意点: 乳幼児や高齢者は、嘔吐による窒息や誤嚥性肺炎で重篤化するケースがまれにあるため注意が必要です。
感染経路と二枚貝
- 循環サイクル: 人の腸→下水→川→海→二枚貝→人というサイクルで循環しています。
- 二枚貝: カキなどの二枚貝は、海水を大量にろ過する際、海中に浮遊するノロウイルスを体内に溜め込んでしまうため、感染源の一つとなります。
- 予防(食事): ノロウイルス汚染の恐れのある食品は、85℃〜90℃で90秒間以上加熱すれば心配ありません。また、「生食用カキ」でも感染リスクはゼロではないため、食品を扱う仕事の人は注意が必要です。
検査方法
病院や検査機関では、主に以下の2種類の検査が行われます。
| 種類 | 特長 | 検査感度 |
|---|---|---|
| 抗原反応(イムノクロマト法など) | ウイルスのタンパク質を検出。病院での簡易検査に使われることが多い。 | 低い(△) |
| 遺伝子検査(RT-PCR法など) | ウイルスの遺伝子を増幅して検出。感度が高く、食品工場や介護施設の調理師などの感染の疑いを調べる際によく利用される。 | 高い(◎) |
予防と消毒
- 予防の基本: 感染対策、特に手洗いの徹底が最も重要です。
- 消毒薬: ノロウイルスはアルコール消毒が効きにくいため、次亜塩素酸ナトリウム(家庭用塩素系漂白剤など)を使用した消毒が推奨されます。
- 嘔吐物の処理: 嘔吐物を処理する際は、必ず次亜塩素酸ナトリウム水溶液で床などを消毒し、汚染の拡大を防ぐことが重要です。嘔吐物にハイターなどを直接かけても効果は薄いため、適切な濃度の消毒液をかける必要があります。
ギョウ虫検査に関して
主に保育園の園児や小中学校の生徒を対象に、健康診断として毎年定期的に行われている尿検査およびギョウ虫検査を行っています。
